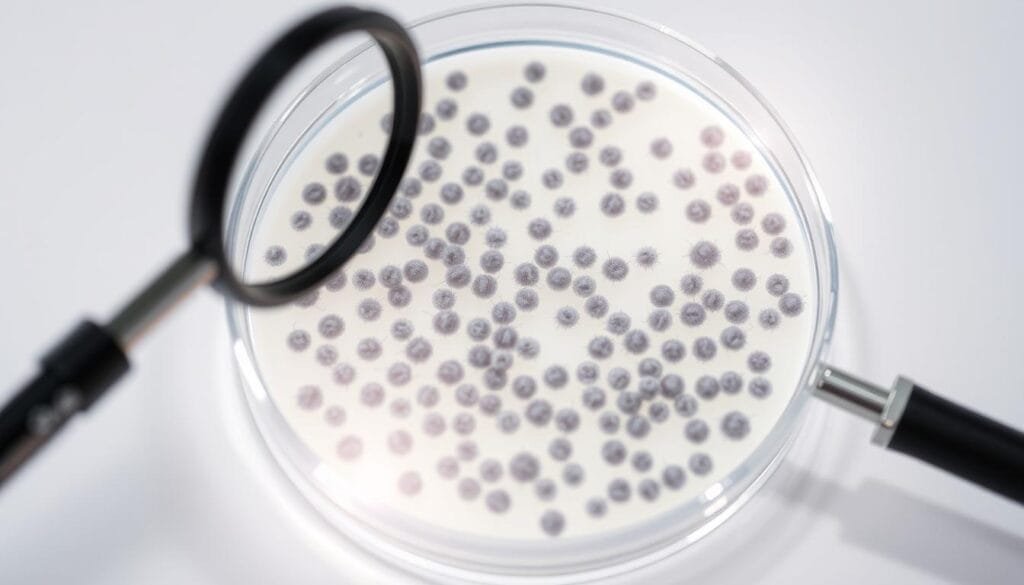
colony counting colony counting

Surprising fact: a standard test can show a result like 1 × 106 CFU/mL, a number that instantly changes how a product is judged for safety and quality.
The term in this entry explains colony-forming unit as the practical unit used in microbiology to estimate how many viable cells are in a sample. Labs dilute and plate a small portion so visible colonies can form. Each colony usually begins from at least one living cell that grew into a dot you can count.
This unit links the observed colonies to a reportable value. It highlights that the count reflects living, multiplying cells rather than every particle present. That focus makes the result meaningful for food, supplements, and routine testing.
For readers in Malaysia who need help interpreting a CFU result, Wellness Concept offers quick responses via WhatsApp at +60123822655 during business hours: Monday–Friday 9:30 am–6:30 pm and Saturday 10 am–5 pm.
Key Takeaways
- A colony-forming unit ties a visible colony to the count of viable cells in a sample.
- Results reflect living cells that can grow, not every cell present.
- Laboratories dilute and plate samples to get a usable, reportable number.
- The unit standardizes how observations become a value for safety checks.
- Wellness Concept can explain a report’s number via WhatsApp during business hours.
What does CFU stand for?
In lab practice, a colony-based count tells how many viable microbes grew from a sample. This shorthand, written as cfu, refers to colony-forming units and reports the approximate number viable rather than every particle seen under a microscope.
In microbiology, the focus is on colonies that arise from bacteria or fungi after incubation. A single colony may start from one cell or a tiny group, so the report uses a practical unit that captures growth potential.
CFU in lab work vs. stem research
By contrast, CFU-F is used in stem and hematopoietic studies to score colony-forming units fibroblasts as a progenitor readout. That usage measures different cells and biological meaning than microbial counts.
“When a report lists cfu without a suffix, it usually refers to microbial colonies; CFU-F will be labeled in stem-focused assays.”
| Aspect | Microbial CFU | CFU-F (stem) |
|---|---|---|
| Target | bacteria, fungi | fibroblast progenitors |
| Meaning | viable growth count | progenitor growth potential |
| Common use | food, supplements, safety | bone marrow research |
If readers in Malaysia need help interpreting a test report, Wellness Concept is available via WhatsApp at +60123822655 during business hours.
Why CFU estimates viable cells in a sample
Plate counts focus on organisms that can grow when placed in defined laboratory settings. This method uses specific conditions — temperature, time, and medium — so only those able to reproduce form a visible colony.
Colonies arise under controlled growth conditions
Plating gives an operational way to estimate number of organisms capable of expansion. If a single cell or small group divides, it becomes a colony on the plate.

This focus means the assay reports the number viable, which is often more useful for safety and quality decisions than counting all particles present.
Undercounting factors: chains, clumps, and progenitor groups
Many microbes in nature do not exist as solitary units. Some bacteria form chains (like Streptococcus) or clumps (like Staphylococcus), so one colony can represent several cells.
- This aggregation is a key factor that can lead to underestimation by colony-forming units.
- Gentle mixing may break clumps, but harsh agitation can harm delicate organisms and reduce recovery.
Despite these limits, the method remains standard because it links visible colonies to organisms that actually grow. For readers in Malaysia needing help to interpret a report or the number in context, Wellness Concept can assist via WhatsApp at +60123822655 during working hours.
How colony-forming units are measured on agar plates
Counting colonies on agar relies on careful dilution and measured plating to turn a busy sample into readable data. This section outlines how labs move from a concentrated original sample to a reliable value on an agar plate.
Serial dilutions and plating volumes
Labs usually make ten-fold dilutions so very dense material becomes countable. Typical plated volumes range from 100 μL to 1 mL to balance separation and readability.
Calculating CFU/mL or CFU/g
To back-calculate the colony-forming unit per mL or per gram, combine the observed colonies, the dilution factor, and the plated volume. For example, colonies × dilution factor ÷ plated volume gives the value in the original sample.
Common plating methods
Pour plate: sample mixed with molten agar at ~40–45 °C, then incubated so colonies grow within the agar.
Spread plate: a small volume is spread across the surface to isolate colonies for easy counting.
Membrane filter: used when larger volumes are needed; the sample is filtered and the membrane placed on nutrient agar.
Drop-plate (Miles & Misra): tiny aliquots (≈10 μL) are dropped in zones. Read early to avoid merging colonies.
Log notation and technique tips
Concentrations are often shown in base-10 logs: 10⁶ CFU/mL = 6 log10 CFU/mL. Log reduction is the subtraction between logs.
Consistent pipetting, even spreading, clean agar, and suitable plates improve precision when turning colonies into a trusted number.
“Careful technique at the plate stage is the difference between a rough estimate and a reportable value.”
If Malaysian labs need method help or advice on choosing an approach, Wellness Concept can be contacted via WhatsApp at +60123822655 during business hours.
Tools and techniques for counting colonies
Counting colonies on a plate can be done by hand, with software, or by automated instruments.
Manual counting and practical tips
Manual counting uses a pen and a click-counter. The user marks each colony on the plate surface while tallying to keep the count traceable.
When colonies are too numerous, labs count a defined fraction of the dish or use plates within the target range to report accurate cfu units.
Software-based enumeration
OpenCFU, ImageJ macros, and CellProfiler pipelines analyze photos to speed counts and record colony size and color.
Mobile apps for Android and iOS let teams snap a plate image and export results into lab records for routine research or quality work.
Automation and alternative plating
Automated counters pair cameras with algorithms to standardize counts across assays. They save time but come with higher costs and less flexibility.
Spiral plating reduces the number of plates by generating a concentration gradient on one plate, helping labs capture readable zones quickly.
“Algorithms can mistake dust or scratches for a colony, so a human check is still essential.”
| Approach | Best use | Pros | Cons |
|---|---|---|---|
| Manual (pen & click) | Low throughput | Low cost, visible trace | Slow for many plates |
| Software (OpenCFU / ImageJ) | Moderate throughput | Fast, objective metrics | Depends on photo quality |
| Automated counter | High throughput | Consistent, fast | High purchase cost |
Some automated methods avoid staining so the cell remains viable for downstream assays, but labs must weigh cost, plate volume, and desired traceable outputs.
Malaysian teams can ask Wellness Concept for pointers on time-saving tools via WhatsApp at +60123822655 during business hours.
Alternative units and complementary assays
Complex matrices sometimes hide living microbes from agar, so other units and assays estimate what plates miss.
Most Probable Number for low counts or particulate samples
Most Probable Number (MPN) is a statistical method that estimates viable cells when direct colonies won’t resolve. Labs use dilution series and growth/no-growth patterns to infer counts.
MPN suits turbid water, environmental samples, and foods with particulates that block clear colonies. It gives a defensible number when plate reads fail.
Modified Fishman Units and viable-but-non-culturable cells
Modified Fishman Units (MFU) broaden interpretation to organisms that survive but refuse to grow on standard media. This concept captures viable-but-non-culturable bacteria and fungi missed by plate counts.
MFU-style approaches complement colony-forming units and help when recovery is known to be limited.
“No single approach covers every sample; pairing methods often gives the best evidence.”
| Scenario | Recommended unit | Why |
|---|---|---|
| Clean food/spores low interference | colony-forming units | Direct colonies give clear counts |
| Turbid or particulate matrix | MPN | Statistical estimate avoids plating issues |
| Known recovery limits | Modified Fishman Units | Captures viable-but-non-culturable cells |
Labs should match the unit and method to the sample and verify with parallel assays when stakes are high. For advice in Malaysia on choosing CFU, MPN, or other measures, contact Wellness Concept on WhatsApp at +60123822655 during business hours.
Practical notes for researchers in Malaysia
Good lab practice starts at the moment a swab touches a surface or a tube receives blood. Consistent sampling and clear records protect the integrity of the original sample and make results easier to trust.
Collect and document: note the original sample volume, time, and transport conditions. Label plates and record lot numbers so experiments are reproducible.
Choose media and incubation that match the matrix. Blood-containing media and environmental swabs need tailored handling to avoid visual artifacts when reading plates.
Validate recovery with positive controls using known cells. For studies that include stem culture systems or a progenitor readout, clearly separate those workflows from microbial units in reports.
“A clear chain of custody from collection to counting supports credible reporting.”
Quick checklist
- Standardize collection and transport for each sample.
- Record plate type, lot, and incubation settings.
- Share plate images and count sheets for audits.
- Review handling steps if expected colonies do not appear.
| Issue | Action | Why it matters |
|---|---|---|
| Transport delay | Use cold chain or process quickly | Preserves viable cells |
| Blood matrix | Adjust lighting and interpretation | Reduces false reads |
| Collaborations | Share images and units calculations | Ensures transparent audits |
Wellness Concept welcomes WhatsApp messages from Malaysian teams at +60123822655. Business hours: Mon–Fri 9:30 am–6:30 pm, Sat 10 am–5 pm, Sun Closed. They can advise on methods, interpretation, and reporting.
Conclusion
, A colony-forming unit ties visible growth on an agar plate to a reported value in microbiology. It shows how colonies counted on plates plus dilution and plated volume produce the final number, often given in log10.
Reliable results depend on the right method — pour, spread, membrane, or drop-plate — and care with agar, incubation, and dilutions. Automated counters and software speed counts but need checks for artifacts, especially on blood media or dirty surfaces.
When plating limits appear, MPN and Modified Fishman Units can extend the evidence. CFU-F remains a distinct progenitor readout in stem work and should be reported separately.
For practical help in Malaysia, contact Wellness Concept on WhatsApp at +60123822655 (Mon–Fri 9:30 am–6:30 pm; Sat 10 am–5 pm; Sun Closed).
FAQ
Understanding CFU: What does CFU stand for? – Wellness Concept
In microbiology, the term refers to a colony-forming unit, an estimate of viable cells in a sample based on the number of colonies that grow on an agar plate. In stem cell work, CFU-F denotes colony-forming units–fibroblast, used to quantify progenitor or stem-like cells that form adherent colonies under defined culture conditions.
CFU in microbiology vs. CFU-F in stem cell contexts
The microbiology usage counts viable bacteria or fungi that produce visible colonies. CFU-F applies to mammalian cultures where each colony originates from a progenitor cell capable of proliferation. Both measure reproductive potential, but methods and interpretation differ between agar-based plating and tissue-culture assays.
Why CFU estimates viable cells in a sample
Colony counts reflect cells able to reproduce and form colonies under the chosen growth conditions, so the resulting value approximates the number of viable, culturable units rather than total cells or genomes detected by molecular tests.
Colonies arise under controlled growth conditions
When a sample is incubated on nutrient medium, individual viable units multiply into visible colonies given suitable temperature, atmosphere, and time. Growth conditions strongly influence which organisms will form colonies and be counted.
Undercounting factors: chains, clumps, and progenitor groups
Cells that stick together, grow in chains, or originate from small clusters produce one colony but represent multiple viable cells. This causes colony counts to underestimate actual viable cell numbers unless dispersion methods and proper dilution are applied.
How colony-forming units are measured on agar plates
Technicians perform serial dilutions to obtain plates with countable colonies, then spread or pour a known volume. After incubation, they count colonies and multiply by the dilution factor to calculate CFU per milliliter or per gram of original sample.
Serial dilutions and plating volumes for countable colonies
Common practice uses tenfold dilutions and plating volumes like 0.1 or 1.0 mL. Choosing a dilution that yields 30–300 colonies on a plate improves accuracy and statistical reliability for the resulting estimate.
Calculating CFU/mL or CFU/g using dilution factors
The formula multiplies the colony count by the inverse of the plated fraction and the dilution factor. For example, 50 colonies from 0.1 mL of a 10^-4 dilution equals 50 × 10 × 10^4 = 5 × 10^6 CFU/mL of the original sample.
Common plating methods: pour plate, spread plate, membrane filter, and drop-plate (Miles and Misra)
Pour plates embed sample in molten agar, spread plates distribute sample on surface, membrane filters trap microbes for transfer to agar, and drop-plate or Miles and Misra uses small drops for rapid, resource-light counts. Choice depends on sample type and lab resources.
Log notation for CFU concentrations and log reduction
Microbial loads often use logarithmic notation for compact expression and to quantify changes. A one-log reduction equals a tenfold decrease; log scales help compare treatments and antimicrobial efficacy across wide ranges.
Tools and techniques for counting colonies
Manual counting with click counters remains common for low-throughput work. For higher throughput, software and automated counters speed enumeration and reduce observer bias.
Manual counting with click-counters and marking
Technicians mark colonies on the plate bottom or a transparent overlay and tally with a click counter. This low-cost method works well when colony density stays within a countable range.
Software-based enumeration: OpenCFU, ImageJ/CellProfiler, and mobile apps
Open-source tools like OpenCFU and ImageJ plugins, plus CellProfiler pipelines and smartphone apps, automate detection, measure colony size, and export counts. Proper imaging and thresholding are essential for reliable results.
Automated systems and spiral plating: speed, costs, and limitations
Automated colony counters and spiral platers increase throughput and consistency but require higher upfront investment and maintenance. They may struggle with irregular colonies or complex backgrounds.
Alternative units and complementary assays
When plating is impractical, labs may use Most Probable Number (MPN) statistics for low counts or particulate samples. Other approaches target viable-but-non-culturable cells or use molecular methods to complement culture-based estimates.
Most Probable Number (MPN) for low counts or particulate samples
MPN uses serial dilutions and presence/absence results across replicates to estimate viable counts statistically. It suits samples with low organism density or when solids interfere with plating.
Modified Fishman Units (MFU) and viable-but-non-culturable cells
MFU represents alternative viability metrics in specialized contexts. Some organisms enter a viable-but-non-culturable state and evade detection by plating; combining culture with molecular viability assays helps reveal those populations.
Practical notes for researchers in Malaysia
Wellness Concept offers local support and can be reached via WhatsApp at +60123822655. Business hours: Mon–Fri 9:30 am–6:30 pm, Sat 10 am–5 pm, Sun closed. They can advise on sampling, plating, and assay selection for regional labs and field work.

